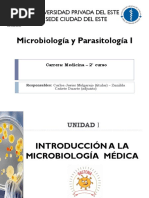

100% encontró este documento útil (1 voto)
167 vistas5 páginasBases Físico-Químicas - Enfermería - SJ
Este documento presenta el plan de estudios del curso de Físico Química para el primer año de la carrera de Técnico Universitario en Enfermería. El curso abarca 11 unidades que cubren temas como introducción a la química y físico química, elementos químicos y la tabla periódica, enlaces químicos, compuestos químicos, soluciones, química biológica, termodinámica, potenciales eléctricos y la luz en el organismo human
Cargado por
Carolina Magali CascoDerechos de autor
© © All Rights Reserved
Nos tomamos en serio los derechos de los contenidos. Si sospechas que se trata de tu contenido, reclámalo aquí.
Formatos disponibles
Descarga como PDF, TXT o lee en línea desde Scribd
100% encontró este documento útil (1 voto)
167 vistas5 páginasBases Físico-Químicas - Enfermería - SJ
Este documento presenta el plan de estudios del curso de Físico Química para el primer año de la carrera de Técnico Universitario en Enfermería. El curso abarca 11 unidades que cubren temas como introducción a la química y físico química, elementos químicos y la tabla periódica, enlaces químicos, compuestos químicos, soluciones, química biológica, termodinámica, potenciales eléctricos y la luz en el organismo human
Cargado por
Carolina Magali CascoDerechos de autor
© © All Rights Reserved
Nos tomamos en serio los derechos de los contenidos. Si sospechas que se trata de tu contenido, reclámalo aquí.
Formatos disponibles
Descarga como PDF, TXT o lee en línea desde Scribd